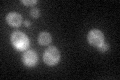
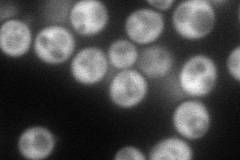
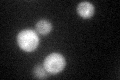

View description
ATPase of the CDC48/PAS1/SEC18 (AAA) family, forms a hexameric complex; is essential for pre-60S maturation and release of several preribosome maturation factors; may be involved in degradation of aberrant mRNAs
Localization:
Intensity:
Fold change:
Significance:
-
C’ GFP library in SD
cytosol36.58 -
N' NOP1pr-GFP in SD
cytosol104.652 -
N' TEF2pr-mCherry in SD

vacuole0 -
N' NATIVEpr-GFP in SD

missing0 -
N' TEF2pr-VC and Cyto-VN in SD

#N/A0 -
C’ GFP library in SD+DTT
cytosol27.440.75No -
C’ GFP library in SD+H2O2

cytosol34.70.94No -
C’ GFP library in Starvation Media

cytosol27.320.74No -
C’ GFP library on the background of Pup2-DaMP

cytosol -
C’ GFP library on the background of CCT mutant

cytosol38.01341.03907No
